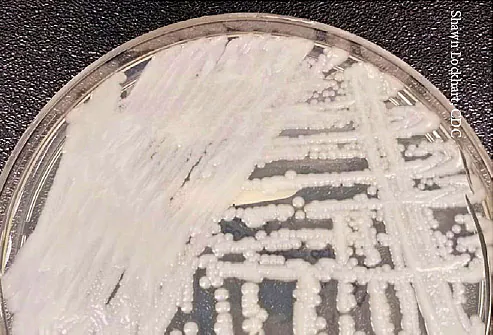

Most Unvaccinated Americans Want to Stay That Way: Poll

By Robert PreidtHealthDay Reporter MONDAY, July 26, 2021 (HealthDay News) — Eight in 10 American adults who haven’t received a COVID-19 shot say they are unlikely to get one, a new survey shows. The results mean “that there will be more preventable cases, more preventable hospitalizations and more preventable deaths,” Dr. Amesh Adalja, an infectious […]
‘Superbug’ Fungus Spreads Among Vulnerable in Two U.S. Cities
By Robert PreidtHealthDay Reporter FRIDAY, July 23, 2021 (HealthDay News) — An untreatable “superbug” fungus is spreading in a Washington, D.C., nursing home and two Dallas-area hospitals, the U.S. Centers for Disease Control and Prevention said Thursday. There were 101 candida auris cases at the nursing home and 22 cases at the hospitals from January […]
She’s Not Just an Olympian. She’s a Mom

Editor’s note: This is the part of a series highlighting the 2021 Olympic Games with a specific emphasis on health and wellness. July 23, 2021 — While thousands of athletes are now competing in the COVID-19-challenged Tokyo Olympics, about a dozen representing Team USA have another distinction: They’re moms. From […]
Drug Makers Reach $26 Billion Deal on Opioid Lawsuits

THURSDAY, July 22, 2021 (HealthDay News) — A proposed $26 billion settlement on opioid-related lawsuits has been reached with four large drug companies, a group of state attorneys general announced Wednesday. If enough states sign on to the deal with the country’s three major drug distributors — Cardinal Health, AmerisourceBergen and McKesson — and pharmaceutical […]
Money Can Buy Americans Longer Life: Study

FRIDAY, July 23, 2021 (HealthDay News) — Money may not buy happiness but new research suggests it may at least help Americans live longer. “Our results suggest that building wealth is important for health at the individual level, even after accounting for where one starts out in life,” said Greg Miller, a faculty fellow […]
CDC Monitors Potential Monkeypox Exposure in U.S.

July 23, 2021 As public health officials keep track of the contagious Delta variant of COVID-19 across the U.S., the CDC is also watching for a potential outbreak of another virus — monkeypox. More than 200 people in 27 states are being monitored for possible exposure after they had contact with an American […]
Prescriptions for Fruits and Vegetables a Blossoming Program

Michel Nischan, co-founder, Wholesome Wave; chef; sustainable food advocate. Wholesome Wave: “Produce Prescription Programs Then and Now” webinar; “2020 Impact Report,” “Produce Prescription Programs: U.S. Field Scan.” Harvard Center for Health Law and Policy Innovation: “Mainstreaming Produce Prescriptions: A Policy Strategy Report,” “New Initiative to Mainstream Produce Rx Programs Promotes Access to Healthy Food for […]
Finding What Works for You

SOURCES: American Psychological Association: “Clinical Practice Guideline for the Treatment of Depression Across Three Age Cohorts.” Harvard Medical School: “What are the real risks of antidepressants?” InformedHealth.org: “Depression: How Effective Are Antidepressants?” Michael E. Thase, MD, chief, mood and anxiety section; professor of psychiatry, Perelman School of Medicine, University of Pennsylvania. Michelle Riba, MD, clinical […]
Man Gets Lifesaving Intestinal Transplant After Bull Attack

Caleb Brooks, intestine transplant recipient, Somerville, AL. Madeline Johnson Brooks, wife of Caleb Brooks, Somerville, AL. Anil Vaidya, transplant surgeon, Cleveland Clinic, Cleveland, OH. Deepak Katyal, trauma and acute care surgeon, Huntsville Hospital, Huntsville, AL. Organdonor.gov: “Organ Donation Statistics.” Statista: “Number of U.S. candidates waiting for selected organ transplants as of September 2020.” American Society […]
Denied Assistant, U.S. Paralympian Drops Out of Games

July 22, 2021 — U.S. Paralympian Becca Meyers, a three-time gold medal swimmer who is deaf and blind, announced this week that she’s dropping out of the Tokyo Games. Meyers said she made the decision because the U.S. Olympic & Paralympic Committee denied her request to bring her personal care assistant to Japan. A […]
